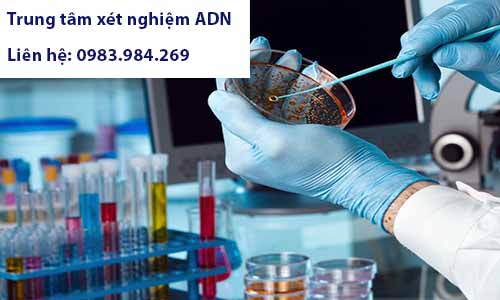

Bạn cần xét nghiệm ADN nhưng không biết địa chỉ xét nghiệm ADN ở Trà Vinh? Bạn cần kiểm tra quan hệ cha con nhưng không biết địa chỉ xét nghiệm ADN nào uy tín? Bạn muốn xét nghiệm ADN thai nhi nhưng lo lắng không biết có an toàn hay không?
Hãy liên hệ với Trung tâm xét nghiệm ADN Trà Vinh qua hotline 0983.984.269. Chúng tôi sẽ tư vấn chi tiết về địa chỉ xét nghiệm ADN ở Trà Vinh, các phương thức xét nghiệm ADN ở Trà Vinh, giá xét nghiệm ADN ở Trà Vinh,… ngoài ra, hãy theo dõi bài viết dưới đây của chúng tôi để tìm hiểu thêm những thông tin bổ ích.

Địa chỉ xét nghiệm ADN ở Trà Vinh
Khách hàng xét nghiệm ADN với nhiều mục đích. Thông qua thủ tục xét nghiệm ADN, người yêu cầu xét nghiệm có thể xác định được quan hệ huyết thống cha con, có thể sử dụng kết quả xét nghiệm ADN để bổ sung hồ sơ hành chính – pháp lý tại cơ quan nhà nước, ví dụ như xét nghiệm ADN để đăng ký khai sinh, xét nghiệm ADN để làm căn cứ khởi kiện, xét nghiệm ADN để làm thủ tục nhập tịch,… Theo đó, tương ứng với mỗi thủ tục xét nghiệm sẽ đem lại những giá trị khác nhau.
Phụ thuộc vào nhu cầu của khách hàng, xét nghiệm ADN ở Trà Vinh sẽ được phân thành các thủ tục khác nhau. Trường hợp người yêu cầu xét nghiệm cần xác định huyết thống, giải tỏa nghi ngờ về huyết thống giữa những người tham gia xét nghiệm thì Trung tâm xét nghiệm ADN Trà Vinh sẽ tư vấn khách hàng thực hiện thủ tục xét nghiệm ADN tự nguyện. Trường hợp khách hàng cần xét nghiệm để thực hiện các thủ tục như: xét nghiệm ADN để làm giấy khai sinh, xét nghiệm ADN nhận cha con, xét nghiệm ADN khởi kiện tại Tòa án, xét nghiệm ADN nhập tịch,… thì sẽ thực hiện theo thủ tục xét nghiệm ADN pháp lý. Ngoài ra, nếu bạn muốn xét nghiệm xác định quan hệ huyết thống trước sinh thì sẽ thực hiện các phương pháp xét nghiệm ADN thai nhi.
Xét nghiệm ADN tự nguyện ở Trà Vinh
Xét nghiệm ADN tự nguyện nhằm xác định quan hệ huyết thống, giải tỏa nghi ngờ giữa những người tham gia xét nghiệm. Bản chất của phương thức xét nghiệm này là để xác định quan hệ huyết thống nên sẽ không đi kèm các thủ tục như đối với xét nghiệm ADN pháp lý. Khách hàng có thể đến trực tiếp địa chỉ xét nghiệm ADN ở Trà Vinh hoặc gửi mẫu xét nghiệm qua đường bưu điện để tối ưu chi phí. Trung tâm xét nghiệm ADN Trà Vinh cũng hỗ trợ trả kết quả bằng file mềm nếu bạn không muốn nhận bản cứng. Thủ tục nói trên diễn ra cụ thể như sau:
- Thứ nhất: Chuyên viên của Trung tâm xét nghiệm ADN Trà Vinh tiếp nhận thông tin và yêu cầu của khách hàng.
- Thứ hai: Chuyên viên của Trung tâm xét nghiệm ADN Trà Vinh tư vấn, hướng dẫn khách hàng tự thu mẫu và cung cấp địa chỉ xét nghiệm ADN ở Trà Vinh.
- Thứ ba: Khách hàng gửi mẫu xét nghiệm qua địa chỉ xét nghiệm ADN ở Trà Vinh. Hoặc đến trực tiếp địa chỉ xét xét nghiệm ADN ở Trà Vinh.
- Thứ tư: Trung tâm xét nghiệm ADN Trà Vinh tiến hành tách mẫu và trả kết quả. Kết quả xét nghiệm có thể trả bằng bản mềm (file PDF) hoặc gửi bản cứng về tận nơi.
Thời gian xét nghiệm thông thường từ 12 giờ đến 24 giờ kể từ thời điểm nhận mẫu. Trong trường hợp khách hàng yêu cầu, chúng tôi cũng hỗ trợ gói xét nghiệm nhanh (trả kết quả từ 4 đến 6 giờ kể từ thời điểm nhận mẫu).
Về giá xét nghiệm ADN ở Trà Vinh, do đã tối ưu hóa các thủ tục, chỉ với mục đích duy nhất là xác định huyết thống cha con nên chúng tôi có chi phí xét nghiệm ADN ở Trà Vinh rẻ nhất. Cụ thể, phí xét nghiệm ADN huyết thống cha con thời điểm hiện tại của Trung tâm xét nghiệm ADN Trà Vinh là 1.250.000/mẫu phẩm. Mức phí trên có thể thay đối theo thời gian. Để được tư vấn về chi phí xét nghiệm ADN giá rẻ ở Trà Vinh, hãy liên hệ với chúng tôi qua hotline 0983.984.269 hoặc email xetnghiemadn.tt@gmail.com.
Xét nghiệm ADN pháp lý ở Trà Vinh
Xét nghiệm ADN pháp lý ở Trà Vinh là thủ tục xét nghiệm ADN để khách hàng thực hiện các thủ tục hành chính – pháp lý. Các thủ tục pháp lý phổ biến bao gồm: xét nghiệm ADN để làm giấy khai sinh, xét nghiệm ADN để nhận cha con, xét nghiệm ADN để khởi kiện tại Tòa án, xét nghiệm ADN để nhập tịch,… sau khi xét nghiệm, khách hàng sẽ dùng kết quả xét nghiệm ADN của Trung tâm xét nghiệm ADN Trà Vinh để bổ sung hồ sơ, thực hiện các thủ tục nói trên.
Điểm khác biệt lớn nhất giữa thủ tục xét nghiệm ADN tự nguyện và xét nghiệm ADN pháp lý nằm ở giá trị của kết quả. Kết quả xét nghiệm ADN pháp lý là giấy tờ bắt buộc trong một số thủ tục. Ví dụ như thủ tục đăng ký nhận cha, mẹ, con được quy định tại khoản 1, Điều 24 Luật hộ tịch năm 2014:
“Người yêu cầu đăng ký nhận cha, mẹ, con nộp tờ khai theo mẫu quy định và chứng cứ chứng minh quan hệ cha con hoặc mẹ con cho cơ quan đăng ký hộ tịch. Khi đăng ký nhận cha, mẹ, con các bên phải có mặt.”
Còn đối với xét nghiệm ADN tự nguyện, kết quả xét nghiệm ADN tự nguyện mang tính chất tham khảo nên thủ tục đơn giản hơn. Nói một cách ngắn gọn, xét nghiệm ADN pháp lý sẽ được thực hiện theo thủ tục khác so với xét nghiệm ADN tự nguyện.
Thủ tục xét nghiệm ADN pháp lý sẽ diễn ra như sau:
- Thứ nhất: Trung tâm xét nghiệm ADN Trà Vinh tiếp nhận thông tin và yêu cầu của khách hàng.
- Thứ hai: Trung tâm xét nghiệm ADN Trà Vinh sẽ phân loại và tư vấn và cùng khách hàng thống nhất về các nội dung liên quan.
- Thứ ba: khách hàng có thể lựa chọn đến trực tiếp địa chỉ xét nghiệm ADN ở Trà Vinh để chuyên viên của chúng tôi thu mẫu. Hoặc chuyên viên của Trung tâm xét nghiệm Adn Trà Vinh hỗ trợ thu mẫu tận nhà, cùng với đó là chuẩn bị các giấy tờ như đơn yêu cầu xét nghiệm, biên bản xét nghiệm để khách hàng hoàn thành.
- Thứ tư: Trung tâm xét nghiệm ADN sẽ tiến hành tách mẫu phẩm và trả kết quả cho khách hàng.
Để tham khảo về giá xét nghiệm ADN pháp lý rẻ nhất tại Trà Vinh, hãy liên hệ với chúng tôi qua hotline 0983.984.269 hoặc email xetnghiemadn.tt@gmail.com.
Xét nghiệm ADN thai nhi ở Trà Vinh
Xét nghiệm ADN thai nhi là thủ tục xét nghiệm ADN đặc biệt. Một trong những người được lấy mẫu xét nghiệm là thai nhi (chưa được sinh ra) nên thủ tục xét nghiệm sẽ có những đặc thù riêng. Về bản chất, xét nghiệm adn thai nhi là xét nghiệm tự nguyện, vì một chủ thể chưa thể có năng lực trách nhiệm dân sự khi chưa sinh ra nên kết quả xét nghiệm không thể sử dụng để làm thủ tục hành chính – pháp lý.
Thông thường, sẽ có hai phương pháp để xét nghiệm ADN thai nhi tại Trà Vinh. Cụ thể như sau:
Xét nghiệm ADN thai nhi xâm lấn tại Trà Vinh
Xét nghiệm ADN thai nhi xâm lấn (hay còn gọi là xét nghiệm ADN chọc ối) là việc sử dụng mẫu nước ối, mẫu gai nhau của người mẹ để xét nghiệm. Đồng thời, Trung tâm xét nghiệm Adn Trà Vinh sẽ tách thêm mẫu của người cha giả định để đối chiếu với nhau.
Việc xét nghiệm chỉ được thực hiện khi thai nhi từ 12 tuần tuổi trở lên. Ngoài ra, việc lấy mẫu và xét nghiệm phải được thực hiện trực tiếp tại địa chỉ xét nghiệm ADN ở Trà Vinh, được thực hiện bởi các y, bác sỹ đầy đủ chuyên môn nghiệp vụ. Với đội ngũ nhân lực giỏi chuyên môn, giàu kinh nghiệm cùng với hệ thống máy móc hiện đại, đầy đủ, Trung tâm xét nghiệm ADN Trà Vinh cam kết trả kết quả xét nghiệm ADN thai nhi xâm lấn với thời gian nhanh nhất, kết quả chính xác nhất. Thời gian trả kết quả thông thường của trung tâm chúng tôi là từ 4 đến 6 ngày kể từ ngày tiếp nhận mẫu.
Xét nghiệm ADN thai nhi không xâm lấn tại Trà Vinh
Ngoài sử dụng mẫu nước ối, mẫu gai nhau để xét nghiệm ADN thai nhi, mẫu máu của thai phụ cũng được sử dụng để xét nghiệm ADN đối với những trường hợp con còn trong bụng mẹ. Phương pháp sử dụng mẫu máu của thai phụ để xét nghiệm ADN được gọi là xét nghiệm ADN thai nhi không xâm lấn. Theo đó, Trung tâm xét nghiệm ADN Trà Vinh sẽ sử dụng mẫu máu của người mẹ để xét nghiệm, cùng với đó là xét nghiệm mẫu bất kì của người cha giả định (thường là tóc, móng tay, niêm mạc miệng,…) để có sự đối chiếu với nhau. Phương pháp này được nhiều khách hàng lựa chọn vì tính tiện lợi của nó. Nếu xét nghiệm ADN xâm lấn, thai phụ phải đến địa chỉ xét nghiệm ADN ở Trà Vinh thì với phương pháp xét nghiệm không xâm lấn, khách hàng có thể đến trực tiếp trung tâm hoặc chuyên viên của chúng tôi có thể hỗ trợ thu mẫu tận nơi.
Để có thể xét nghiệm ADN không xâm lấn, thai nhi phải đáp ứng đủ điều kiện về tuổi là từ 7 tuần tuổi trở lên.
Để tham khảo chi tiết giá xét nghiệm ADN thai nhi xâm lấn và giá xét nghiệm ADN thai nhi không xâm lấn, mời bạn liên hệ với chúng tôi qua hotline 0983.984.269hoặc email xetnghiemadn.tt@gmail.com.
Địa chỉ xét nghiệm ADN uy tín ở Trà Vinh
Ngoài xét nghiệm ADN giá rẻ, xét nghiệm ADN chính xác tuyệt đối thì uy tín của Trung tâm xét nghiệm ADN cũng là vấn đề được nhiều khách hàng cân nhắc. Với hệ thống máy móc hiện đại, đội ngũ nhân lực tâm huyết, giỏi chuyên môn, Trung tâm xét nghiệm ADN Trà Vinh là đơn vị được nhiều khách hàng lựa chọn thực hiện thủ tục xét nghiệm ADN.
Hãy liên hệ với chúng tôi để được tư vấn về địa chỉ xét nghiệm ADN ở Trà Vinh, xét nghiệm ADN rẻ nhất ở Trà Vinh, xét nghiệm ADN làm giấy khai sinh ở Trà Vinh, xét nghiệm ADN thai nhi ở Trà Vinh qua các phương thức sau:
Hotline: 0983.984.269
Fanpage: Trung tâm ADN Trà Vinh
Email: xetnghiemadn.tt@gmail.com
Website: Trung tâm xét nghiệm ADN

